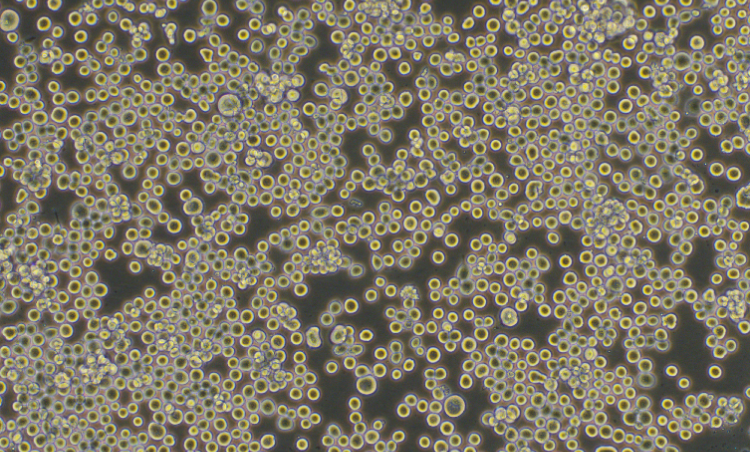
昆蟲卵巢細胞Sf9(種屬鑒定)
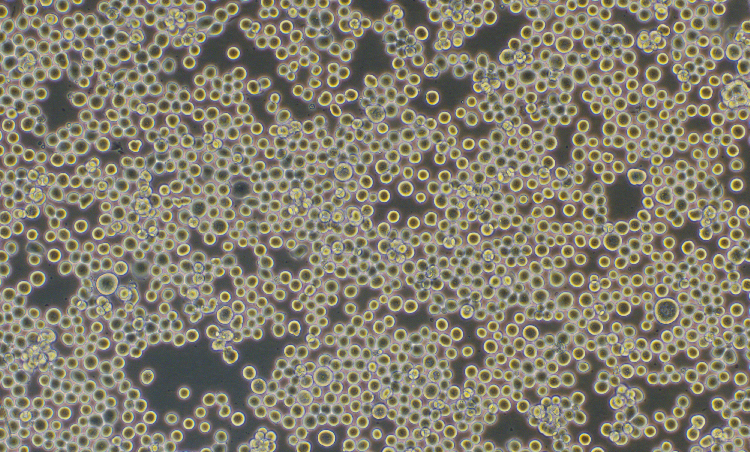
昆蟲卵巢細胞Sf9(種屬鑒定)

|
種屬 |
草地貪夜蛾 |
|
別稱 |
SF9; sf9; SF-9; Sf-9; sf-9; Sf 9; Spodoptera frugiperda clone 9; Sf clone 9; IPLB-Sf-9AE; IPLB-SF-9AE; IPLB-SF-9; IPLB-Sf-9; IPLB-Sf9 |
|
組織來源 |
卵巢 |
|
傳代比例/細胞消化 |
1:2傳代,懸浮部分離心收集(1000RPM,5分鐘),貼壁部分消化1-3分鐘 |
|
完全培養基配置 |
TNM-FH昆蟲培養基;10%胎牛血清;1%雙抗 |
|
簡介 |
Sf9細胞是源于雌性草地貪夜蛾蛹的卵巢組織,可以用于復制桿狀病毒表達載體。 |
|
形態 |
上皮細胞樣 |
|
生長特征 |
貼壁,懸浮混合生長 |
|
倍增時間 |
~50h |
|
培養條件 |
氣相:空氣,100%; 溫度:28攝氏度,培養箱濕度為70%-80%。 |
|
凍存條件 |
凍存液:90%FBS,DMSO 10%, 或使用非程序凍存液:官網貨號JY-H040 |
|
保藏機構 |
ATCC; CRL-1711 |
|
備注 |
該細胞為半懸浮和半貼壁細胞,懸浮細胞離心收集,貼壁細胞消化處理,該細胞為28℃培養,不需要二氧化碳。 |
|
產品使用 |
僅限于科學研究,不可作為動物或人類疾病的治療產品使用。 |